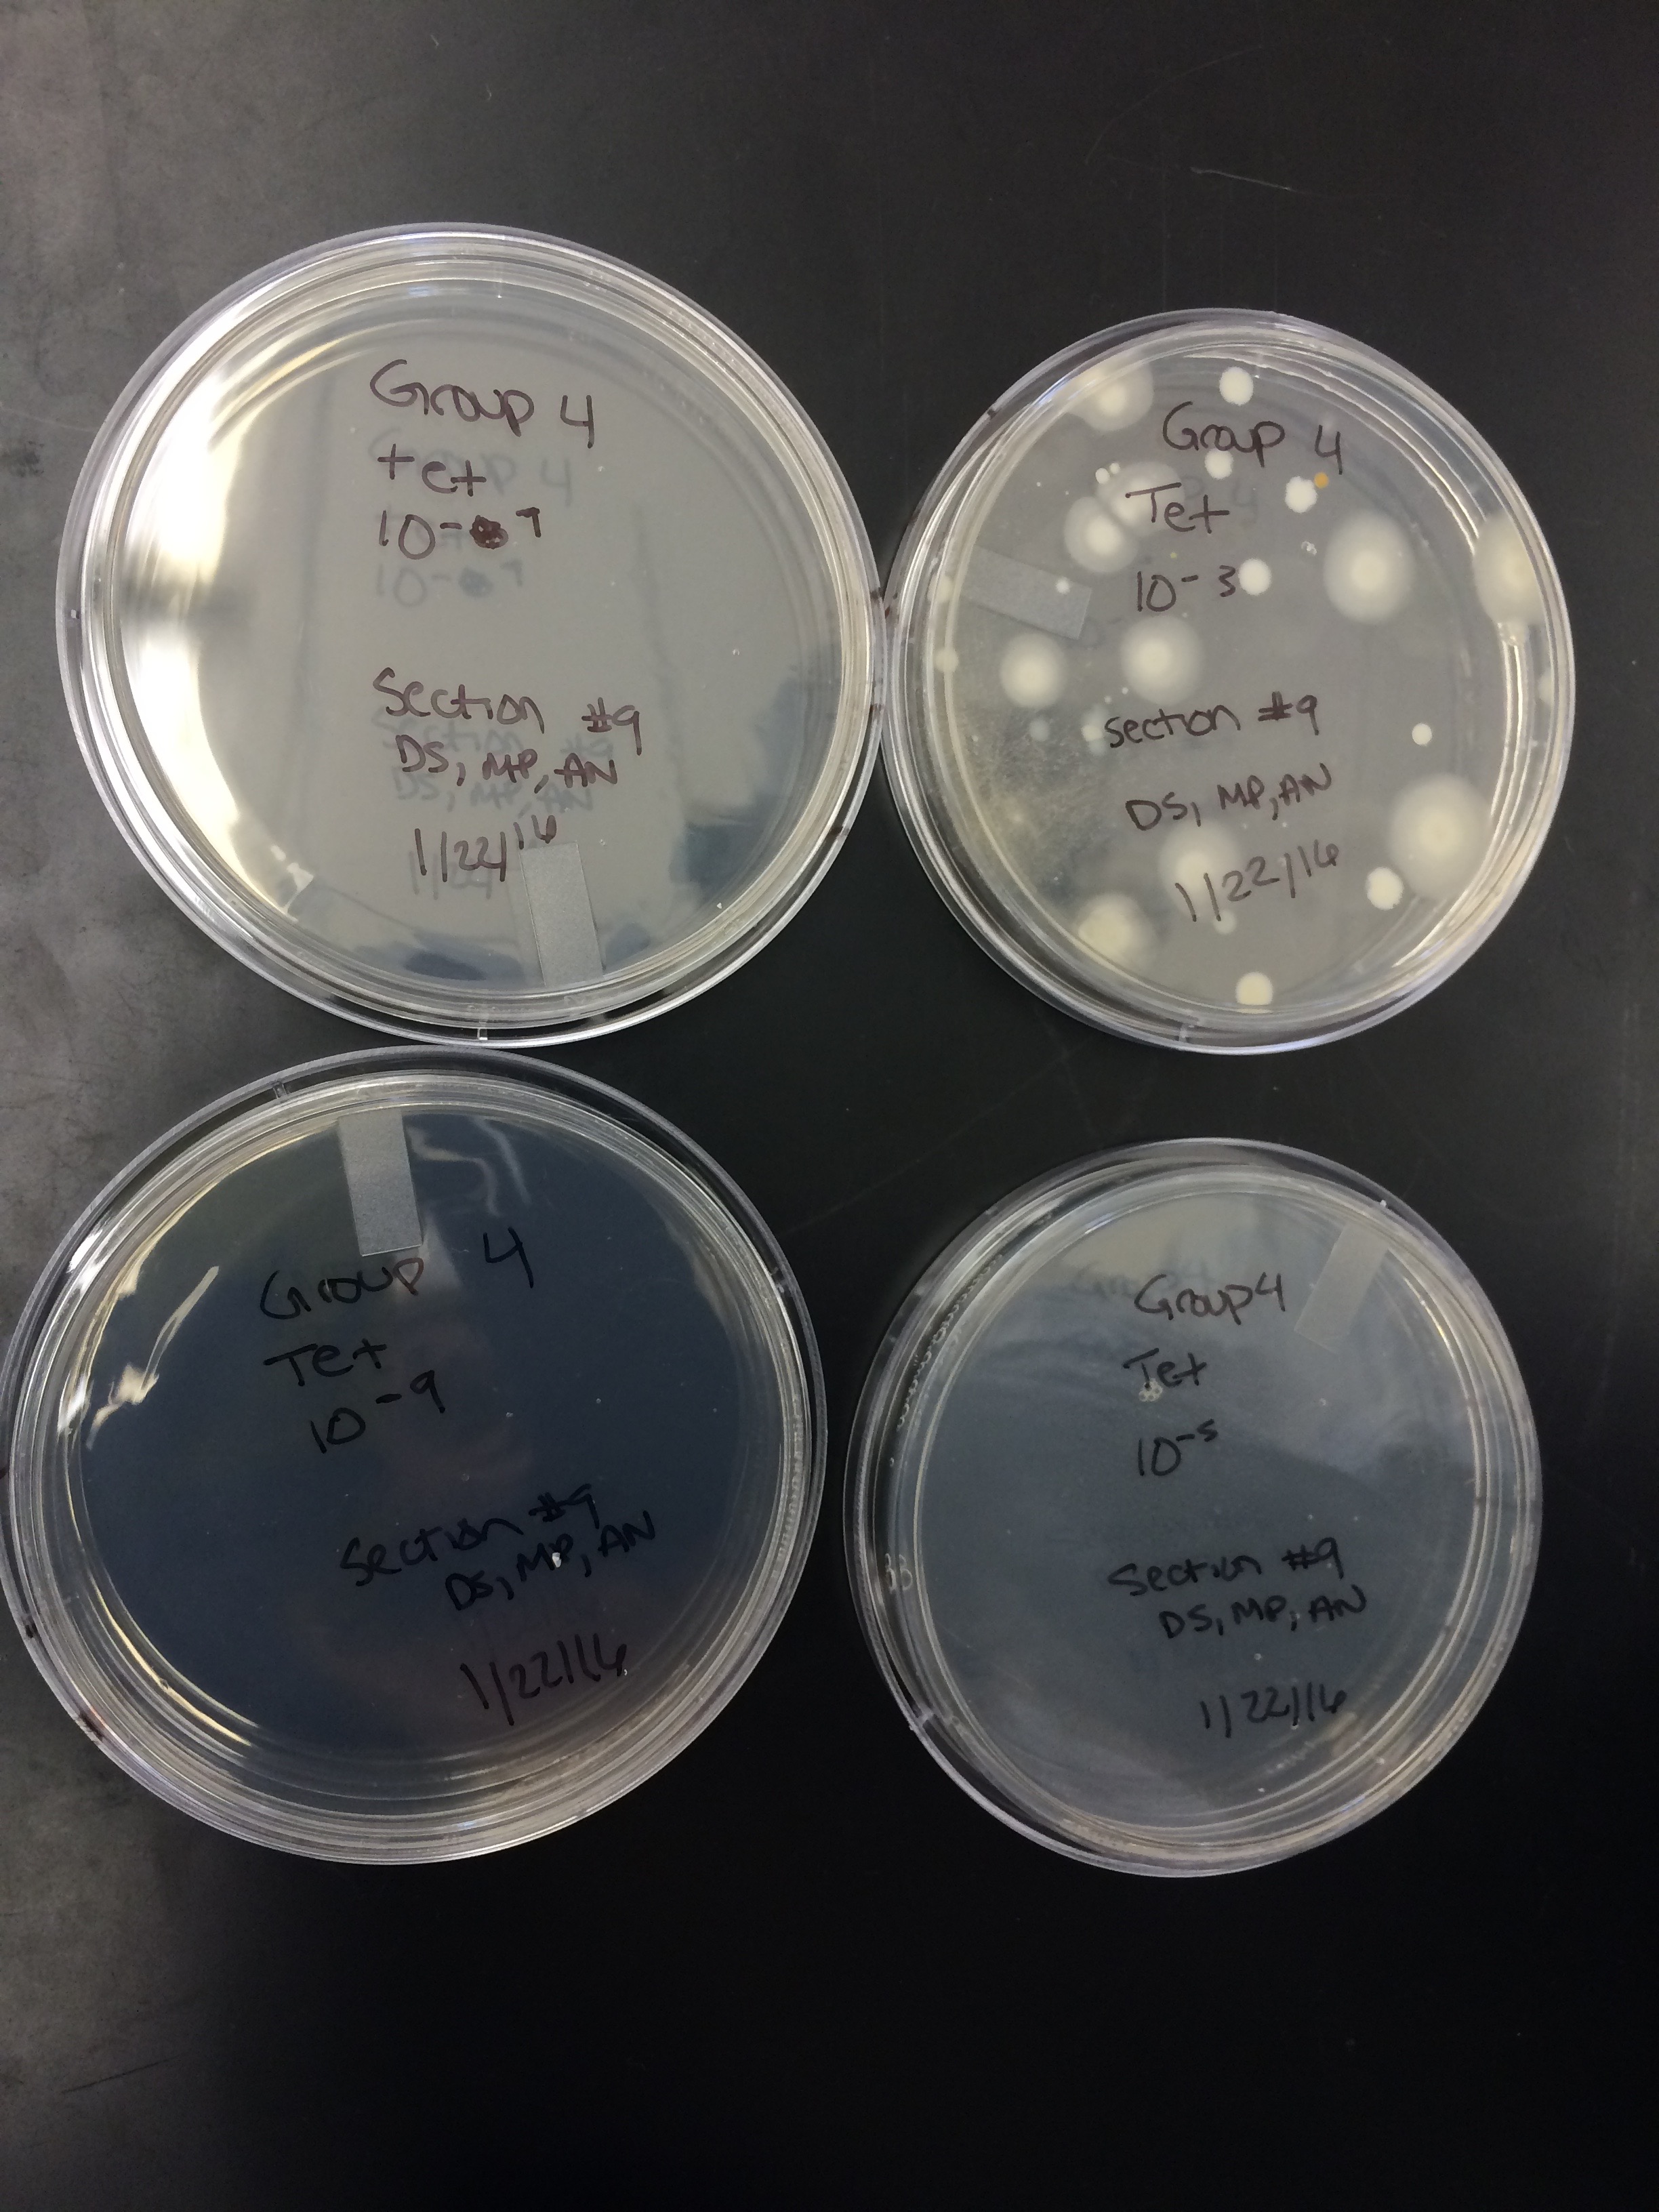

User:Madison Prieto/Notebook/Biology 210 at AU
Zebrafish Experiment
How Fluoride Affects Embryonic Development of Zebrafish
Purpose
Recent increases in the intake of sodium fluoride, especially in dental products, have raised concerns about how fluoride affects embryonic development. A teratogen is something that can disturb the development of the embryo or fetus. The ability of known mammalian teratogens to interact with the embryo to cause fetal malformations suggests that fluoride, as well, likely interacts with the embryo to cause malformation. The teratogenic potential is further supported by evidence that fluoride is able to cross through the placenta and reach the embryo easily (Neff and Goh, 2003). One way to evaluate the effects fluoride has on mammalian embryonic development is to study the effects fluoride has on the development of zebrafish, Danio rerio. Zebrafish have proven to be powerful model organisms for studying vertebrates due to their low cost and external and therefore easily visible embryonic development (Lin and Veldman, 2008). Because zebrafish are vertebrates, studies can be related to other mammals, such as humans. Zebrafish are idea model organisms to further our understanding of how fluoride affects mammalian embryonic development.
Hypothesis
We believe that sodium fluoride will cause significant deformities in the embryonic development of the Zebrafish. Specifically, we believe that the head-tail length of the developing embryos treated with fluoride will be significantly shortened. It is also hypothesized that the embryos treated with fluoride will have lighter pigmentation and smaller eye diameters.
Link to Zebrafish Lab Notebook:
https://docs.google.com/document/d/1ibaB4GC_BGTeJEqA8bpn9itMDU5JsHzqGkUvQWsyjSI/edit
[ Jackie, if you are not able to view this link, I also shared the google doc with you and it should appear in your email.]
M.P.
March 4, 2016 Food Web and Vertebrate Analysis
Purpose
The purpose of both the vertebrate analysis and the construction of the food web is to further support our hypothesis of a diverse ecosystem within transect four. We also learned about ecosystems through learning about communities, carrying capacities, and different trophic levels.
Materials and Methods
To discover what vertebrates inhabit non-tidal marshes, we conducted research. To construct the food web, we read about ecosystems and ecology in chapter 56 of Biological Science, written by Freeman, Quillin, and Allison. On pages 1150 and 1151, the authors explain how trophic structure and energy transfer work in communities. Using this information and the research we found on the vertebrates, we constructed a food web for the organisms in transect four.
Data and Observations
Table of Vertebrates that Inhabit Non-Tidal Marshes:
| Vertebrate | Barn Swallow | Red Winged blackbird | Muskrat | Painted Turtle | Koi Fish |
| Phylum | Chordata | Chordata | Chordata | Chordata | Chordata |
| Subphylum | Vertebrata | Vertebrata | Vertebrata | Vertebrata | Vertebrata |
| Class | Aves | Aves | Mamallia | Reptilia | Actinopterygii |
| Order | Passeriformes | Passeriformes | Rodentia | Testudines | Cypriniformes |
| Family | Hirundinidae | Icteridae | Cricetidae | Emydidae | Cyprinidae |
| Genus | Hirundo | Agelaius | Ondatra | Chrysemys | Cyprinus |
| Species | Rustico | Agelaius phoeniceus | Ondatra Zibethicus | Chrysemys picta | Cyprinus Carpio |
Food web:
This food web illustrates the many interactions between the the organisms at all trophic levels within the non-tidal marsh. At the bottom are the primary producers, the plants that fuel the rest of life. Without the primary producers, few animals would thrive. Here, the painted turtle and the muskrats feed off of the producers. Protists are often photosynthetic, but others feed off of bacteria and algae. Koi fish are omnivores. They eat insects and worms, as well as plants and algae. Painted turtles feed primarily on plants, although they will eat insects, just like the invertebrates we collected. They also feed on algae. Barn Swallow feed mostly on flying insects. Muskrats are primarily herbivores, although they feed on animals as well. They would consume the plants in transect four. The red winged blackbird eats both the flea and the earthworm, but it also eats primary produce, particularly dead leaves and soil (Wohlgemuth 1991).
Conclusion
The food web further supports our hypothesis of a diverse ecosystem within the transect by illustrating the complicated relationships that exist between all of the organisms. Together, the organisms fulfill the concepts of "carrying capacity," "community," and "trophic levels." The food web shows a community, a group of organisms interacting with each other. Like all ecological systems, transect four has a specific carrying community, a limited number of organisms it can support. The trophic levels are indicated by the location of the organism on the food chain. The food web supports the data about the range of organisms we found in our transect. We found everything from bacteria to invertebrates; organisms that are able to support a complicated food web like the food web of transect four.
Citations: http://ccrm.vims.edu/publications/wetlands_technical_reports/91A.pdf
http://animaldiversity.org/accounts/Agelaius_phoeniceus/
M.P.
February 19, 2016 Identify Bacterial Species using PCR
Purpose
The Purpose of this lab was the use the DNA from the Polymerase Chain Reaction and determine which bacteria was present. The PCR sequence analysis shows that despite the usefulness of a Dichotomous Key, it is not the most accurate way of categorizing organisms.
Materials and Methods
The DNA was sent to be analyzed after the Gel Electrophoresis. The bacteria from our transect was analyzed.The sequence we received was entered into an NCBI database to determine what type of bacteria it is.
Data and Observations
The sequence:
NNNNNNNNNNNNNGNNANNCNTGCAGTCGAGCGGTAGTCACNNNNAGCTTGCTCTCGGGTGACGAGCGGCGGACGGGTGA GTAATGTCTGGGAAACTNGCCTGATGGAGGGGGATAACTACTGGAAACGGTAGCTAATACCGCATAACGTCGCAAGACCA AAGAGGGGGACCTTCGGGCCTCTTGCCATCAGATGTGCCCAGATGGGATTAGCTAGTAGGTGGGGTAATGGCTCACCTAG GCGACGATCCCTAGCTGGTCTGAGAGGATGACCAGCCACACTGGAACTGAGACACGGTCCAGACTCCTACGGGAGGCAGC AGTGGGGAATATTGCACAATGGGCGCAAGCCTGATGCAGCCATGCCGCGTGTATGAAGAAGGCCTTCGGGTTGTAAAGTA CTTTCAGCGAGGAGGAAGGCATTGTGGTTAATAACCACAGTGATTGACGTTACTCGCAGAAGAAGCACCGGCTAACTCCG TGCCAGCAGCCGCGGTAATACGGAGGGTGCAAGCGTTAATCGGAATTACTGGGCGTAAAGCGCACGCAGGCGGTCTGTCA AGTCGGATGTGAAATCCCCGGGCTCAACCTGGGAACTGCATTCGAAACTGGCAGGCTAGAGTCTTGTAGAGGGGGGTAGA ATTCCAGGTGTAGCGGTGAAATGCGTAGAGATCTGGAGGAATACCGGTGGCGAAGGCGGCCCCCTGGACAAAGACTGACG CTCANNTGCGAAAGCGTGGGGAGCAAACAGGNANNAGATACCCTGGTAGTCCACGCCGTNNCGATGTCGACTTGGAGGTT GTTCCCTTGAGGAGTGGCTTCCGGAGCTAACGCGTTAANTCGACCGCCTGGGGANTACGGCCGCANNGTTAAAACTCAGA TGAATTGACNGGGGNNCGCACAANCGGTGGNGCNNGTGGTTTAATTCGATGCAACGCGAANNANCCNTNACCTACTCTTG ACATCCNNANAACTTAGCNNNGATNCTTTNGTGCCTTCNNNAACTNNNNNNCAGGTGCTGCNNGGCTNTCGTCNNNCNTG NN
is 96% similar to Enterobacteria, a gram negative, bacillus shaped bacteria.
Conclusion
The bacteria found in our transect in the Gram Stains were all found to be gram negative. The Enterobacteria is also gram negative, therefore our data is consistent with what we found in transect four.
M.P.
February 12, 2016 Exercise 5: Observing Invertebrates
Purpose
The purpose of this lab is to show the range of diversity in the invertebrates of transect four using a Dichotomous Key. Another purpose is to learn about symmetry of animals and discover the main differences between protostomes and deuterosomes, as well as coelomates, acoelomates, and pseudocoelomates.
Materials and Methods
First, we observed the acoelomate, nematodes, and the coelomate Annelida. We then broke down the Berlese Funnel and poured the top 10-15 mL of 50% ethanol and organisms into a petri dish. We poured the remaining organisms into a second dish. We observed the invertebrates with a dissection microscope.
Data and Observations
Table of Invertebrates collected from Berlese Funnel:
| Organism (Phylum and Class) | Length in mm | Number in Sample | Description of Organism |
| Anthropod, Insect | 3 | 1 | Fly; has wings and antennae |
| Anthropod, Insect | 2 | 1 | Flea; compressed legs used for jumping |
| Anthropod, Insect | 2.5 | 1 | Lice; pointy head, organism's back is curved |
The table above shows the description of invertebrates found in transect four. One invertebrate found was a fly, identified by wings and antennae. The flea that was found was identified by compressed legs, fit for jumping. The lice was identified by the shape of the head and back.
Image of Flea from Transect Four:
Image of Lice from Transect Four:
Conclusion
We were only able to identify three invertebrates from our Berlese Funnel. We accredit this to the lack of soil or leaves from below the sample in the transect. The lack of organisms may have also been due to the cold temperatures; the organisms may not have been at the surface or an inch below the surface of the ground. The organisms we measured ranged from 2mm to 3mm. The largest organism was the fly and the smallest organism was the flea.
M.P.
February 5, 2016 Exercise 4: Plantae and Fungi
Purpose The primary purpose of this lab is to show the unique characteristics of plants that have evolved by observing the diversity of plants in our transect. We will describe the main characteristics and differences of plants and fungi and learn the differences between angiosperms and bryophytes. Another purpose is to understand alternation of generations and to be able to identify the structure and the function of the reproductive parts of a flower.
Materials and Methods Procedure one was to collect five plant samples from our transect. We had to collect at least 500 grams of leaf litter. This litter will be used for the Berlese Funnel to collect invertebrates. We then compared the moss and the lily that were set up in the lab. We characterized the vascularization and leaves of each plant in our transect. We then identified the leaves as each plant as monocot or dicot. To set up the Berlese Funnel, pour 25 mL of the 50:50 water/ethanol solution into the 50 mL conical tube. Place a piece of screening material at the bottom of the funnel. Take the material in place if necessary. Place the leaf litter into the funnel. Set up the funnel on a ring stand so that it is held in the tube with the ethanol. Parafilm the base of the funnel so that the ethanol does not evaporate. Place a 40 watt lamp with an incandescent bulb 1-2 inches from the leaf litter. Cover funnel with foil.
Data and Observations
Plant Characterizations Table
| Transect Sample Plants | Location and # in Transect | Description (size and shape) | Vasculatization | Specialized Structures | Mechanisms of Reproduction |
| #1 | East | 4x4 ft round bush | Dicot | Stomata | seeds |
| #2 | NW | 1 ft yellow tufted grass | Monocot | Stomata | seeds |
| #3 | South | 1 inch green grass | Monocot | Stomata | seeds |
| #4 | West | small green bush | Dicot | Stomata | seeds |
| #5 | West | small green grass sprout | Monocot | Stomata | seeds |
The five plants identified from our transect were the 4x4 ft round bush (only plant that had flowers), 1 ft yellow tufted grass, 1 inch green grass, 2x3 rectangular bush, and 3 inch tall pronged green shoot. The plants were identified as monocot or dicot based on their leaf structure and vascular bundles. All of the plants had stomata, and these plants were all angiosperms, meaning they all use seeds as a mechanism of reproduction.
Plant #1: 4x4 ft round bush
Plant #2: 1 ft yellow tufted grass
Plant #3: 1 inch green grass
Plant #4: Small green bush
Plant #5: Small green grass sprout
The fungi sporangia is a bunch of hyphae that have grown together that contains spores inside of the structure. The sporangia is important because when it opens, the spores are released and this is how fungi reproduce. We looked at two types of fungi. The first, we identified as Ascomycota. We know this is a Ascomycota because it is a fuzzy mold.
Picture of Ascomycota:
The second fungi, we identied as Basidiomycota. We know this is a Basidiomycota fungi because it is a mushroom. Picture of Basidiomycota:
Conclusion
This study found that all five of the plants we chose were angiosperms and vascular in nature. Three of the plants we chose were monocot and two were dicot. The same specialized structure was identified in all of these plants, and that was Stomata. All plants reproduced by spreading seeds, because they are all angiosperms. We identified the fungi as Basidiomycota and Ascomycota. Next week’s lab will determine the different invertebrates living in our transect.
M.P.
January 29, 2016 Exercise 3: Microbiology and Identifying Bacteria
Purpose The purpose of this lab is to examine the diversity of bacteria in our Hay Infusion. We will observe the diversity of the morphological characteristics of bacteria. By using Tetracycline, we will test for antibiotic resistance in bacteria. We will also use gram stains to identify different types of bacteria. Finally, we will use PCR and DNA sequencing to verify our identification of the bacterial species in our transect.
Materials and Methods
Procedure one was to observe the bacterial growth on the agar plates and count the colonies. Procedure two involved observing bacteria and cell morphology with prepared slides. We then prepared wet mounts and gram stains with the bacteria from our agar plates. To make a wet mount, sterilize a loop over a flame and scrape up a small amount of growth from the surface of the agar plate. Mix it into a drop of water on a slide and put a cover slip on the drop. Observe using 10x and 40x. To make a gram stain, sterilize a loop over a flame and scrape up a small amount of growth from the agar plate. Mix into a drop of water on a slide. Circle the area underneath the sample with a red wax pencil. Label the slides. Heat fix the air-dried slide by passing it through a flame three times with the bacteria smear side up. Rinse the stain off. Cover the bacterial smear with Gram's iodine mordant for one minute. Rinse the stain off. De-colorize by flooding the bacterial smear with 95% alcohol for 10-20 seconds. Rinse gently. Cover the smear with safranin stain for 20-30 seconds. Rinse stain. Blot excess water carefully with a kimwipe from the side of the slide and let air dry. Do not place a coverslip on. Focus with low magnifications. Procedure three involved setting up PCR. Label two PCR tubes with transect number, colony identifier, and group number. Add 20 microliters of primer/water mixture to a labeled PCR tube. Mix to dissolve the PCR bead. Using a sterile toothpick, pick up a small amount of a bacterial colony. Submerge the toothpick in the primer/water mix and twist for 5 seconds. Discard toothpick. Cap the tube and place in PCR machine.
Data and Observations
Our Hay Infusion was only different this week in that there was more of a film over the surface of the water, and the Hay Infusion smelled more strongly of mildew. The smell might have changed because there are now more organisms that are living inside of the Hay Infusion.
Serial Dilutions Results Table:
Bacteria Characterization Table:
Note: All were viewed at 40x magnification.
Gram Stain Tetracycline 10^-3:
Conclusion
It is simple to see that the bacterial growth was significantly inhibited by the tetracycline. One Tetracycline plate, 10^-3, the one with the least amount of antibiotic, showed bacteria growth. This plate, however, only grew 40 colonies of bacteria, which is much less in comparison to the nutrient agar plates. One of the nutrient agar plates grew up to 1 million colonies.
After viewing the results of the gram staining, all of our plates were gram negative. This means that the bacteria have less peptidoglycan in their cell walls. The gram negative bacteria were very responsive to tetracycline .
M.P.
January 22, 2016 Exercise 2: Identifying Algae and Protists
Purpose The purpose of this lab is to use a Dichotomous Key to identify protists from our Hay Infusions and to learn the defining characteristics of protists. We will also identify and characterize the protists in our transect. We then did serial dilutions to plate the bacteria and characterize the bacterial diversity.
Materials and Methods Procedure one involved making a wet mount from the Hay Infusion to observe with the microscope at 4x and 10x. Focus on an organism, describe it, and record its size. Use the Dichotomous Key to identify organisms. Procedure two involved prepare for next week’s microbiology lab by preparing agar plates. We obtained four nutrient agar and four nutrient agar plus tetracycline plates. We performed serial dilutions for the bacteria to grow on each plate. We added bacteria to each plate and let the plates sit at room temperature for a week.
Data and Observations
Our Hay Infusion was filled halfway with brown dirty water. There was some dead plant life sitting at the bottom on top of sand or dirt that had collected at the bottom of the jar. All of the plant life looked destroyed. There was a sort of film over the surface of the water. We took samples from the top, middle and bottom of the Hay Infusion and viewed the samples under a microscope.
We used the Dichotomous Key to determine what protists were living in our Hay Infusion.
Description of cell from bottom of hay infusion: -Cell is colorless -Cell is stagnant -Cell is not spherical -Shape of cell remains constant -Seems as if cell has very thick cell walls -Parts of cell would range from 2-30 ocular spaces at 100x -This protist sample is a type of algae known as Pandorina.
Description of cell from middle layer of hay infusion: -4 ocular spaces (at 10x objective) -small body -oval shaped -fast swimmer -Colpidium
Description of cell from top layer of Hay Infusion: -random, quick movements, -cell compresses as it is moving -10 ocular spaces -Stentor
Another cell from top layer of Hay Infusion: -5 ocular spaces -colonies -Gloeocapsa
Another cell from top layer of Hay Infusion: -150 ocular spaces -resembles a large blob -Hydrodictyon
Conclusion In this lab, we identified that the samples from our Hay Infusion were full of life. In our samples, we saw both algae and protists, supporting our hypothesis that there would be many biotic factors in our hay infusion. We also used a Dichotomous Key to characterize and learn about the protists and algae in our Hay Infusions. Next week's lab will reveal even further analysis on the biodiversity of our transect through examining the bacterial diversity from the samples.
M.P.
January 15, 2016 Exercise 1: Examining Biological Life at AU
Purpose The purpose of this week's lab experiment was to examine and compare different members of the Volvocine Line and to examine the biodiversity on the campus of American University. At the end of the lab, we set up a Hay Infusion with abiotic and biotic compontnets found in our transect.
Materials and Methods Procedure one involved examining members of the Volvocine Line: Chlamydomonas, Gonium, and Volvox. We recorded the colony size, number of cells, specialization of these cells, and whether the cell was isogamous or oogamous under the microscope. Procedure two involved going to our transect and recording everything we observed. We also took samples of our transect and brought the samples back to the laboratory. Procedure three involved making a Hay Infusion. To do this, we placed 10-12 grams of our sample into a jar with 500 mLs of deerpark water, added 0.1 gram of dried milk, and mixed the jar for 10 seconds.
Data and Observations Transect Four included many different biotic and abiotic factors. The abiotic factors included rocks, water, soil and benches. The biotic factors included trees, bushes, flowers, fishes, and many organisms. This transect was interesting to survey and collect from. There is so much plant life and animal life, although we were only able to view the organisms under the microscope. A majority of the plant life was wilted and brown due to the cold weather.
Conclusion Transect four had many abiotic and biotic components to it. These abiotic and biotic components will help us examine the biodiversity at AU. Further experiments will show the different types of organisms that live in transect four at American University.
M.P.